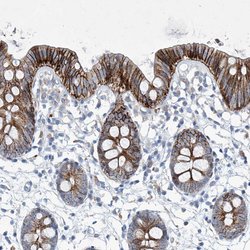
Invitrogen FPR2 Polyclonal Antibody 100 &mu;L; Unconjugated:Antibodies,

missing translation for 'onlineSavingsMsg'
Learn More
Learn More
Invitrogen™ FPR2 Polyclonal Antibody


Rabbit Polyclonal Antibody
Brand: Invitrogen™ PA556076
This item is not returnable.
View return policy
Description
Immunogen sequence: DTYCTFNFAS WGGTPEERLK VAITMLTARG Highest antigen sequence identity to the following orthologs: Mouse - 63%, Rat - 63%.
Formyl peptide receptor 2 (FPR2) is a low affinity receptor for N-formyl-methionyl peptides. Binding of FMLP to FPR2 causes activation of neutrophils. The response is mediated via a G-protein that activates a phosphatidylinositol-calcium second messenger system. The activation of LXA4R could result in an anti-inflammatory outcome counteracting the actions of proinflammatory signals such as LTB4.
Specifications
| FPR2 | |
| Polyclonal | |
| Unconjugated | |
| FPR2 | |
| ALXR; E330010I07Rik; fMLPR1; FMLP-related receptor I; FMLP-R-I; FMLP-R-II; FMLPX; formyl peptide receptor 2; formyl peptide receptor, related sequence 2; formyl peptide receptor, related sequence 2-like; formyl peptide receptor-like 1; Formylpeptide receptor-related sequence 2; FPR2; FPR2A; FPRH1; FPRH2; Fprl1; Fprl-1; FPR-like 1; Fpr-rs1; Fpr-rs2; HM63; Lipoxin A4 receptor; lipoxin A4 receptor (formyl peptide receptor related); lipoxin A4 receptor-like protein; Lipoxin receptor; LXA4 receptor; LXA4R; N-formyl peptide receptor 2; N-formylpeptide receptor-like 2; RFP | |
| Rabbit | |
| Antigen Affinity Chromatography | |
| RUO | |
| 2358 | |
| Store at 4°C short term. For long term storage, store at -20°C, avoiding freeze/thaw cycles. | |
| Liquid |
| Immunohistochemistry (Paraffin) | |
| 0.1 mg/mL | |
| PBS with 40% glycerol and 0.02% sodium azide; pH 7.2 | |
| P25090 | |
| FPR2 | |
| Recombinant protein corresponding to Human FPR2. Recombinant protein control fragment (Product #RP-90881). | |
| 100 μL | |
| Primary | |
| Human | |
| Antibody | |
| IgG |
Product Content Correction
Your input is important to us. Please complete this form to provide feedback related to the content on this product.
Product Title
Spot an opportunity for improvement?Share a Content Correction